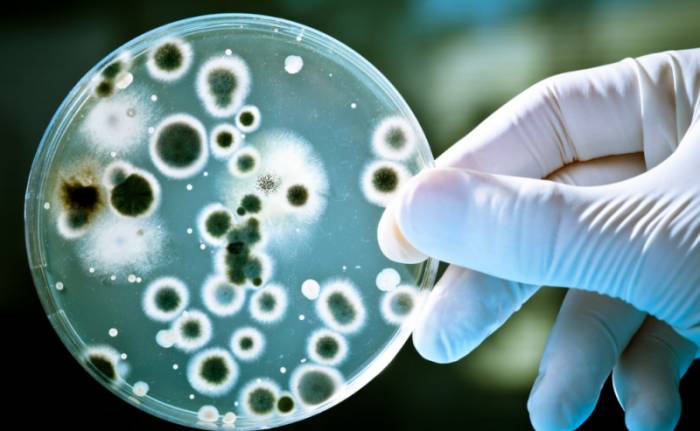
Микробиологический метод

У каждой болезни есть свои определенные симптомы. Используя их, а также опираясь на диагностические исследования врачам намного легче выбрать правильное лечение и в кратчайшее время помочь больному победить недуг.
Хламидиоз

Такого нельзя сказать про хламидиоз. Это болезнь, которая в частых случаях протекает без симптомов и реже может проявиться незначительными отклонениями.
Главное затруднение при диагностике хламидий вызвано их крохотными параметрами и неспособностью роста в искусственно созданных питательных условиях.
Для того чтобы выявить хламидию, находящуюся внутри клетки цилиндрического эпителия, одного мазка из уретры будет недостаточно. Нередко бывает, что у хламидиоза выявляются некоторые симптомы, но они очень похожи на признаки других инфекций, передающихся половым путем. Поэтому, чтобы точно поставить диагноз при подозрении на хламидиоз необходимо провести не одно лабораторное исследование.
Врачи подчеркивают важность своевременной диагностики хламидиоза, так как это заболевание часто протекает бессимптомно. Специалисты рекомендуют проводить регулярные обследования, особенно для людей с повышенным риском, таких как молодые люди и те, кто имеет несколько половых партнеров. Современные методы диагностики, включая ПЦР и серологические тесты, позволяют точно выявить инфекцию. Врачи отмечают, что раннее обнаружение хламидиоза способствует более эффективному лечению и снижает риск осложнений, таких как бесплодие или воспалительные заболевания органов малого таза. Регулярные проверки и информирование пациентов о рисках инфекции играют ключевую роль в борьбе с распространением хламидиоза.
https://youtube.com/watch?v=qwZWDIUbQHA
Кого в первую очередь желательно проверить на хламидиоз?

Есть люди, которые рискуют заболеть этим недугом больше, чем все остальные. К ним в первую очередь относятся:
Что необходимо исследовать?

Для того чтобы обнаружить хламидии в организме нужен не один материал. Их можно выявить в соскобе влагалища, шейки матки, секрета предстательной железы, уретры, глаз. Для достоверности диагностики хламидиоза нужна кровь, моча и мужская сперма.
Есть много анализов, с помощью которых можно выявить хламидиоз. Нужно рассмотреть все из них, чтобы сделать вывод, какому из них отдать предпочтение.
Диагностика хламидиоза вызывает у людей множество вопросов и обсуждений. Многие отмечают, что важность своевременного выявления инфекции трудно переоценить, так как хламидиоз может протекать бессимптомно, но при этом вызывать серьезные осложнения. Некоторые пациенты делятся опытом, что обращение к врачу и прохождение тестов помогли им избежать дальнейших проблем со здоровьем.
Среди распространенных мнений — необходимость регулярного обследования, особенно для активных сексуальных партнеров. Люди также подчеркивают, что современные методы диагностики, такие как ПЦР и серологические тесты, делают процесс более точным и быстрым. Однако не все знают о том, что важно не только пройти тест, но и следовать рекомендациям врача по лечению и профилактике. В целом, осведомленность о хламидиозе и его диагностике растет, что способствует более ответственному отношению к своему здоровью.
https://youtube.com/watch?v=sKxaQTT_vrg
Цитологический анализ

Этот метод помогает только в случаях острых форм недуга и имеет точность определения урогенитального хламидиоза около 12%. Следует учитывать, что хламидии являются внутриклеточными паразитами, поэтому обычного мазка для их определения недостаточно. Необходим соскоб из пораженного органа. Это может быть влагалище, шейка матки, простата, уретра, глаза. Соскоб окрашивается специальным веществом, что дает возможность заметить хламидию под микроскопом.
Иммуноцитологический анализ (РИФ)

Данный метод помогает напрямую определить наличие антигенов хламидий. Для этого исследуемый материал нужно обработать специальными антителами, которые, в свою очередь, были подвергнуты обработке флуоресцирующим препаратом. С помощью этого метода можно определить не только острую форму заболевания, но и хроническую.
Недостатки метода

Иногда результаты анализов бывают ложными, что считается одним из минусов данного исследования. Ложноотрицательный анализ может быть из-за нарушений в правилах забора исследуемого материала. Ложноположительные чаще всего проявляются на фоне других, сочетающихся с хламидиозом инфекционных заболеваний половой сферы. К таким помехам приводит присутствие иной микрофлоры. Данный метод сложен для малоопытных работников лаборатории и не всегда точен. Кроме этого, с помощью него трудно подвести итоги терапии. Вероятность выявления урогенитального хламидиоза составляет не более 50%.
Иммуноферментный анализ (ИФА)

Он не в состоянии распознать хламидии напрямую. С его помощью выявляются антитела к ним. У этого метода есть свои преимущества. Он определяет возбудителя недуга, стадию его развития, а также эффективность терапии.
Как оценить результаты?

Появление антител после заражения паразитами наблюдается на 5–20 сутки. Каждый их класс возникает при той или иной стадии недуга.

Важно знать, что присутствие антител к хламидиям не может повлиять на стойкость иммунитета против бактерий.
Определить наличие хламидий с помощью этого метода можно с точностью до 70% по той причине, что присутствие антител к данной бактерии может проявляться и у здорового человека, который ранее болел хламидиозом.
Полимеразная цепная реакция (ЦПР)

Этот метод помогает выявить фрагменты ДНК бактерии в материале для анализов. Это исключает возможность перепутать данное заболевание с другой инфекцией. Его эффективность наблюдается во всех стадиях. Результат исследований известен уже через пару суток. Материал берется из всех возможных очагов заражения. Случаются ложноположительные результаты. Их причиной могут послужить нарушения в заборе материала, его транспортировке и во время самого исследования.
Важно помнить, что эффективность терапии можно проверить этим методом только по истечении 30 дней после лечения. Это поможет избежать ложноположительного ответа.
На данном этапе этот метод считается самым высокоэффективным. Его точность – 100%.
Микробиологический метод
Он помогает определить хламидии и выбрать антибиотик, к которому они проявляют чувствительность.
Для проведения данного метода необходимо в лаборатории высеять материал для исследования и вырастить его. Процесс этот трудоемкий и дорогостоящий, требует высокой квалификации лаборантов.
Важно знать, что в этом случае нежелательно применение антибиотика за 30 дней до анализа.
Из минусов, кроме трудоемкости и дороговизны метода, считается длительность его проведения. Результат можно узнать только через неделю. Точность исследования – 90%.
Экспресс-диагностика

Она включает в себя ферментспецифическую реакцию и иммунохроматографию. Результаты данного анализа можно узнать уже через 20 минут после забора материала, но точность его составляет всего 25%.
Из всего вышеперечисленного можно сделать вывод, что 100% метода определения хламидиоза не существует. Поэтому для постановки верного диагноза необходимо провести как минимум два из них. Только так можно добиться точной постановки диагноза, правильно назначить лечение в самое максимально короткое время избавиться от недуга.
https://youtube.com/watch?v=qwZWDIUbQHA
Вопрос-ответ
Какой самый точный анализ на хламидиоз?
ПЦР является одной из наиболее распространенных и объективных методик определения хламидийной инфекции, так как позволяет выявить наличие хламидий путем обнаружения следов ДНК возбудителя. Достоверность исследования достигает 100 %. Для проведения диагностики также может быть использована моча.
Какой метод считается золотым стандартом для диагностики хламидиоза?
Для диагностики хламидиоза чаще всего применяется тестирование методом амплификации нуклеиновых кислот (МАНК), которое считается золотым стандартом диагностики C. Trachomatis.
Как врачи определяют хламидиоз?
Развитие хламидиоза провоцируют внутриклеточные паразиты — хламидии (Chlamydia trachomatis). Их очень сложно выявить даже при заборе мазка из половых органов. Для детальной диагностики хламидиоза у мужчин и женщин делают анализ крови или специальный соскоб, который берут с мочеиспускательного канала и шейки матки.
Советы
СОВЕТ №1
Регулярно проходите медицинские обследования, особенно если у вас есть рискованные факторы, такие как наличие нескольких половых партнеров. Раннее выявление хламидиоза может предотвратить серьезные осложнения.
СОВЕТ №2
Обратите внимание на симптомы, такие как болезненное мочеиспускание, выделения из половых органов или боли внизу живота. Если вы заметили что-то из этого, немедленно обратитесь к врачу для диагностики.
СОВЕТ №3
Используйте средства защиты, такие как презервативы, чтобы снизить риск передачи хламидиоза и других инфекций, передающихся половым путем. Это особенно важно при случайных половых контактах.
СОВЕТ №4
Не стесняйтесь обсуждать свои опасения и результаты тестов с вашим врачом. Открытое общение поможет вам получить необходимую информацию и поддержку в лечении и профилактике хламидиоза.









